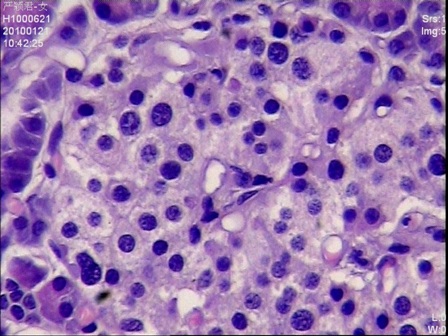
Figure 4: Islet cells with hyperchromatic nuclei and clear abundant cytoplasms (H&E stain, 400 x magnifications)

Case Report

Hyperinsulinemic hypoglycemia due to diffuse nesidioblastosis in adults
Nan Xiang, Chi-hua Fang, Ying-fang Fan, Jian Yang
- Department of Hepatobiliary Surgery, Zhujiang Hospital, The Southern Medical University, Guangzhou 510282, Guangdong, P.R. China
- Submitted: January 31, 2013;
- Accepted February 18, 2013;
- Published: May 18, 2013
This is an Open Access article distributed under the terms of the Creative Commons Attribution License (http://creativecommons.org/licenses/by/3.0), which permits unrestricted use, distribution, and reproduction in any medium, provided the original work is properly cited.
Background
Nesidioblastosis is a rare cause of adult-onset hyperinsulinemic hypoglycemia. We describe a 28-year-old lady who presented with sudden loss of consciousness. Hyperinsulinemic hypoglycemia was found.
Material and Methods
Preoperative imaging’s and intraoperative ultrasound failed to identifiy any pancreatic insulinoma. Selective intra-arterial calcium stimulation with venous sampling showed an elevated insulin level within the distal splenic vein. Open distal pancreatectomy was performed.
Results
Histopathology confirmed nesidioblastosis.
Conclusions
Her recovery was uneventful.
Keywords
Hyperinsulinemic hypoglycemia; Adult nesidioblastosis; Distal pancreatectomy, insulinoma.
Introduction
Persistent hyperinsulinemic hypoglycemia caused by functionally defective β-cells in nesidioblastosis is the most common pathological substrate in newborns. Instead, hyperinsulinemic hypoglycemia in adults is most commonly caused by an insulinoma. Adult nesidioblastosis is an uncommon cause of hyperinsulinemic hypoglycemia characterized by diffuse islet hyperplasia with beta-cell hypertrophy and atypia [1]. Laidlaw introduced the term nesidioblastosis nearly 70 years ago to describe diffuse proliferation of pancreatic islet cells budding from exocrine ducts [2]. The diagnosis of nesidioblastosis may be difficult with functional and anatomical imaging modalities. The diagnosis should be considered when imaging studies and microscopic inspection fail to localize an insulinoma. Since the first reported series of adult onset nesidioblastosis by Harness et al in 1981, only a limited number of cases have been described.

Figure 1: Selective venous sampling from the splenic vein draining different parts of the pancreas.
We report herein a very rare case of nesidioblastosis presenting with acute loss of consciousness.
Table 1: Intraoperative levels of insulin and blood glucose in the peripheral blood and in the splenic vein draining different parts of the pancreas.
|
Insulin
(mIU/L)
|
Blood glucose
(mmol/L)
|
| Peripheral blood |
46.3 |
7.4 |
| Tail of pancreas |
267.7 |
7.4 |
| Juncture between body and tail of pancreas |
1230.7 |
7.3 |
| Body of pancreas |
202.0 |
7.4 |
| Neck of pancreas |
48.7 |
7.2 |
| Head of pancreas |
167.3 |
7.4 |
Case Report
A 28 years old lady admitted for sudden loss of consciousness. She had no history of diabetes mellitus or hypoglycemia. On physical examination, she had stable hemodynamic parameters (blood pressure 120/68 mmHg; pulse 89/minute; respiratory rate 21/minute; oxygen saturation, 99%). Her Glasgow Comatose Score (GCS) was 6. Cardiac rhythm was sinus rhythm. Her serum glucose level was 3.2mmol/L at the first measurement (reference range: 3.5-5.5 mmol/L). Following correction of hypoglycemia, her comatose condition was not improved. Her serum insulin was 89.6 mIU per liter (reference value: 10.0 – 20.0 mIU per liter) and C-peptide was 3.9 μg per liter (reference value: 0.6 – 3.2 μg per liter). Her insulin release index (IRI/G) exceeded 0.4 (reference values less than 0.3). Endocrine examinations to exclude other causes of hypoglycemia, such as hypopituitarism and adrenal insufficiency, were within the normal range. The symptoms and the results of serological tests were consistent with those of insulin-producing lesions including an insulinoma.

Figure 2: Resected surgical specimen
Computed tomography (CT) scan of brain was normal. Abdominal Ultrasound, CT scan and digital substraction angiogram (DSA) failed to detect an endocrine tumor. Electroencephalogram (EEG) showed half-baked basic rhythms, with irregular waves, and unhealthy regulation and amplitude.

Figure 3: Multiple enlarged islets were diffusely present in the pancreatic parenchyma with variations of the size and number of cells in the islets (H&E stain, 200 x magnifications)
Given the negative preoperative findings, exploratory laparotomy was performed 16 days after admission. No pancreatic mass was detected by palpation or by intraoperative ultrasound. Selective intra-arterial calcium stimulation with selective venous sampling of the splenic, superior mesenteric and portal veins (Figure 1) showed an elevated insulin level of 1230.7mIU/L within the distal splenic vein. (Table 1) Distal spleno- pancreatectomy was performed. (Figure 2) Histopathology showed nesidioblastosis with ductuloinsular complexes and insulin-positive cells budding off the duct epithelium. Focally, the distribution of islets was densely crowded. In the majority of islets, multiple β-cells with enlarged and hyper chromatic nuclei and abundant clear cytoplasm were identified (Figure 3 and 4). Immuno histochemically, the number of insulin-secreting β-cells was increased, and the number of glucagon secreting α-cells was decreased.
Figure 4: Islet cells with hyperchromatic nuclei and clear abundant cytoplasms (H&E stain, 400 x magnifications)
The postoperative course was uneventful. Postoperatively, she displayed no signs of recurrent hypoglycemia. The blood sugar levels rose gradually to normal. The glucose and insulin levels were well controlled. (Table 2) She regained consisciousness on post-operative day 80 and was discharged home on postoperative day 47. On follow up 30 months after the operation, she had no clinical evidence of recurrence of nesidioblastosis.
Table 2: The relationship between the rate of infusion of 50% dextrose with the levels of glucose, insulin, C- peptide and insulin release index after operation.
|
Rate of 50% dextrose infusion (mL/h) |
Blood glucose (mmol/L) |
Insulin (mIU/L) |
C-peptide (µg/L) |
Insulin release index (IRI/G) |
| Day 1 |
10.0 |
10.3 |
8.3 |
1.1 |
0.05 |
| Day 2 |
8.0 |
8.9 |
3.8 |
1.1 |
0.02 |
| Day 3 |
5.0 |
9.2 |
15.0 |
2.5 |
0.09 |
| Day 4 |
3.0 |
7.3 |
18.0 |
4.0 |
0.14 |
Discussion
Inappropriate insulin secretion causing hypoglycemia in adults is usually caused by an insulinoma. By contrast, insulinoma is rarely seen in neonates and infants, and persistent hyperinsulinemic hypoglycemia of infancy or congenital hyperinsulinism usually arises from focal hyperplasia (focal pancreatic adenomatous hyperplasia) or diffuse hyperplasia (nesidioblastosis or nesidiodysplasia) of the pancreas. Adult nesidioblastosis is an uncommon cause of hyperinsulinemic hypoglycemia characterized by diffuse islet hyperplasia with beta-cell hypertrophy and atypia. The incidence of nesidioblastosis in adults is unknown, but it is generally thought to be very low.
The first case of infant nesidioblastosis was reported by Laidlaw et al. in 1938 [2]. The first case of adult nesidioblastosis was reported by Sandler et al. in 1957 [3]. Up till now, the number of adult nesidioblastosis reported is less than one hundred. The cause of the functional dysregulation is unknown. It could be a genetic defect, or a reactive process in response to the metabolic and hormonal changes to the substantial weight loss after gastric bypass surgery carried out for morbid obesity.
Establishing the diagnosis of nesidioblastosis in an adult is a great challenge in endocrinology. It is not possible to diagnose diffuse nesidioblastosis in adults on clinical grounds. Thompson et al. proposed five clinical features of nesidioblastosis in adults [4]: 1) postprandial hyperinsulinemic hypoglycemia; 2) negative 72-hour fast; 3) negative perioperative imaging studies for insulinoma; 4) positive calcium stimulation test, and 5) islet hypertrophy or nesidioblastosis. Klöppel et al. proposed histopathologic major and minor criteria for the diagnosis of diffuse nesidioblastosis in adults [5]. The major criteria included: 1) exclusion of an insulinoma macroscopically, microscopically, and immune histochemically; 2) multiple β cells with an enlarged and hyper chromatic nucleus and abundant clear cytoplasm; 3) islets showing normal spatial distribution of various cell types; 4) endocrine cells without proliferative activity. The minor criteria included: 1) enlarged islets; 2) increased number of islets; 3) lobulated islet structure; 4) macro nucleoli in β cells. The major criteria are present in all cases and are essential for diagnosis. The minor criteria are present in some but not all cases.
Surgery is the only potentially curative treatment because long-term medical therapy is unsatisfactory. The extent of surgery is controversial and there is no optimum procedure for all adult patients with nesidioblastosis. It is not possible to predict recurrence of nesidioblastosis based on the histopathologic features encountered in the pancreatic resection specimen. The favorable outcome of our patient suggested that when arterial calcium stimulation and venous sampling showed an abnormal insulin response in one region of the pancreas, complete recovery from hypoglycemia could be obtained by resection of that region.
Conclusion
In conclusion, diffuse nesidioblastosis in adults should be considered as a differential diagnosis in hyperinsulinemic hypoglycemia.
Authors' Contribution
Conflict of Interests
Ethical Considerations
Funding
This paper is supported by the following grants: National High-tech Research and Development Projects (863) (Grant No. 2006AA022346); National Natural Science Foundation (Grant No.81170458); the Natural Science Foundation of Guangdong Province, China (Grant No. 6200171); the integration project of industry, education and research jointly funded by Guangdong Province and the Ministry of Education of P. R. China (Grant No.2009B080701077); the strategic cooperation project jointly funded by Guangdong Province and the Chinese Academy of Sciences (Grant No. 2010A090100032); the Science and Technology Project of Guangdong Province, China (Grant No. 2011B031800088; Grant No. 2011B03180091).
Acknowledgement
We thank Mr. LAU Wan Yee (Prof. from The Chinese University of Hong Kong, Shatin, Hong Kong SAR, China) for proofreading of this article in English.
References
[1]. Klöppel G, Anlauf M, Raffel A, Perren A, Knoefel WT. Adult diffuse nesidioblastosis: genetically or environmentally induced? Hum Pathol. 2008;39:3-8. [Pubmed].
[2]. Laidlaw GF. Nesidioblastoma: The islet cell tumor of the pancreas. Am J Pathol 1938;14:125-39. [Pubmed].
[3]. Sandler R, Horwitz DL, Rubenstein AH ,et al. Hypoglycemia and endogenous hyperinsulinism complicating diabetes mellitus.Application of the C-peptide assay to diagnosis and therapy. Am J Med,1975,59:730-736. [Pubmed].
[4]. Thompson GB, Service FJ, Andrews JC, et al. Noninsulinoma pancreatogenous hypoglycemia syndrome: An update in 10 surgically treated patients. Surgery 2000;128:937-45. [Pubmed].
[5]. Raffel A, Krausch M, Anlauf M, et al. Diffuse nesidioblastosis as a cause of hyperinsulinemic hypoglycemia in adults: a diagnostic and therapeutic challenge. Surgery 2007;141:179-84.[Pubmed].


